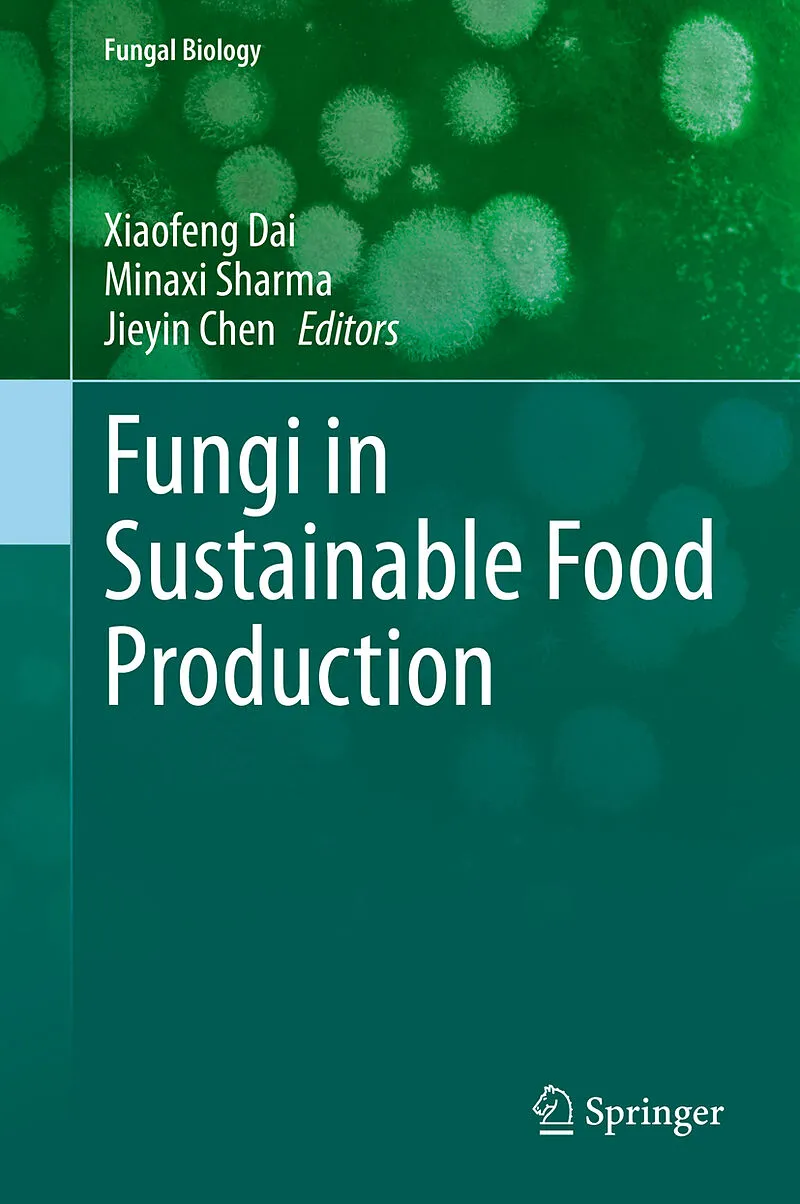

Beschreibung
Presents research on the challenges and potential of fungal contribution in agriculture for food substantiality Includes insights into use of microbial consortia for food processing of biobased products Bridges across topics related to prospects, investment, ...Presents research on the challenges and potential of fungal contribution in agriculture for food substantiality Includes insights into use of microbial consortia for food processing of biobased products Bridges across topics related to prospects, investment, and intellectual and technical issues related to fungal contribution in agriculture
Autorentext
Xiaofeng Dai is currently working as the Director general of The Feed Research Institute, CAAS (Chinese Academy of Agricultural Sciences) and took charge The Director general of the Institute of Food Science and Technology, CAAS (2010 Octerber 2019 May). He supervised Doctoral students, has made outstanding contributions: national agricultural scientific research talents, extinguish young expert appointed by the Ministry of Agriculture of The People's Republic of China, recipient of the special allowance from the State Council, chief scientist of team of the national agricultural science and technology innovation project, leading talent of the Academy of Agricultural Sciences and many more. Dr. Dai had presided over more than 20 national issues, won 4 of National Science and Technology Awards, 6 Provincial Science and Technology Awards, the National "Five-year" Science and Technology Major Achievements Award, "National Five-year Science and Technology Scientist" Award from the state council and contribution awards of "national medium and long-term planning of science and technology strategy", and published more than 200 papers. His research team had been awarded as "outstanding scientific research innovation team of Ministry of Agriculture ".
Dr. Minaxi Sharma is currently working as ERA Chair VALORTECH-Senior Research Scientist, Estonian University of Life Sciences (EMU), Tartu, Estonia. Before joining EMU- Estonia, she worked as Assistant Professor for two years with teaching and research responsibilities, in the Department of Food Technology, Eternal University, Baru Sahib, Himachal Pradesh, India. She obtained her doctorate degree in Dairy Chemistry from National Dairy Research Institute, Karnal (India). She has 9+ years of extensive experience in the research area of: applications of antimicrobial nanoencapsulation of plant essential oils in dairy foods for the enhancement of shelf life (doctoral), probiotic-Indian dairy products (postdoctoral) and in the area of development of functional foods using micro/nano-colloidal delivery systems of potential plant bioactive components (postdoctoral). She is a well-recognized researcher has Web of Science Researcher ID: L-9405-2019; ORCID: https://orcid.org/0000-0001-6493-5217. She is in editorial board of few international journals including, Medicinal Plants - International Journal of Phytomedicines and Related Industries (ISSN: 0975-4261), Microbial Biosystems (ISSN 2357-0334), Egypt and EUREKA: Life Sciences (ISSN 2504-5695), Estonia. She is also the member of Society for Bioinformatics and Biological Sciences (SBBS). She is Visiting Assistant Professor, Department of Botany at Sri Avadh Raj Singh Smarak Degree College, Bishunpur Bairiya, Gonda (affiliated to Dr. RML Avadah University, Ayodhya, UP, India, (July 2019-); and Visiting Faculty, Department of Food Technology at Akal College of Agriculture, Eternal University, Baru Sahib, Himachal Pradesh, India (February 2020). She has published good few peer reviewed papers in internationally well reputed journals.
Jieyin Chen worked in the Institute of Food Science and Technology, Chinese Academy of Agricultural Sciences (2013 January 2020 March) and now is currently working as professor at The Institute of Plant Protection, CAAS. He devotes himself on the research of phytopathogen and food quality and safety, and, has published over 40 papers.
Klappentext
This book presents research on the challenges and potential of fungal contribution in agriculture for food substantiality. Research on fungi plays an essential role in the improvement of biotechnologies which lead global sustainable food production. Use of fungal processes and products can bring increased sustainability through more efficient use of natural resources. Fungal inoculum, introduced into soil together with seed, can promote more robust plant growth through increasing plant uptake of nutrients and water, with plant robustness being of central importance in maintaining crop yields. Fungi are one of natures best candidates for the discovery of food ingredients, new drugs and antimicrobials. As fungi and their related biomolecules are increasingly characterized, they have turned into a subject of expanding significance. The metabolic versatility makes fungi interesting objects for a range of economically important food biotechnology and related applications. The potential of fungi for a more sustainable world must be realized to address global challenges of climate change, higher demands on natural resources.
Inhalt
Preface
1. Fungi as edible food
Prof. Gerardo Díaz-Godínez
Laboratorio de Biotecnología,
Centro de Investigación en Ciencias Biológicas,
9 Universidad Autónoma de Tlaxcala, Ixtacuixtla, Tlax.
México
Email: diazgdo@hotmail.com
2. Fungal production of food ingedients
Dr. M.A. Díaz De Rienzo
School of Chemical Engineering and Analytical Science,
The University of Manchester, Manchester, M13 9PL, UK,
Email: mayri.diazderienzo@manchester.ac.uk, mayriales@gmail.com
3. Fungal production of biological active protein
Dr. Vishal Prasad
Assistant Professor
Institute of Environment and Sustainable Development
Banaras Hindu University
Varanasi-221005
Cell No. +91-9161863763
Email: ways2good@gmail.com
4. Fungal production of dietry fibers
Dr. Peter C.K.Cheung
Food and Nutritional Sciences, School of Life Sciences,
The Chinese University of Hong Kong, Hong Kong, China.
Email: petercheung@cuhk.edu.hk
5. Fungal glycans
Dr. Anthonia O'Donovan,
Applied Biology and Biopharmaceuticals Sciences,
Department of Science,
Galway-Mayo Institute of Technology, Galway, Ireland,
Email: toniodonovan@gmail.com
6. Fungal productions of bicatalysis for food applications
Dr. Hyungdon Yun
Department of Bioscience and Biotechnology,
Konkuk University, South Korea,
Email: hyungdon@konkuk.ac.kr
7. Funagl production of biobased products
Dr. Brent Erickson,
Biotechnology Industry Organization (BIO),
Industrial & Environmental Section, 1201 Maryland Ave., SW, Suite 900,
Washington, DC 20024, USA
E-mail: berickson@bio.org
8. Fungal mycotoxins
Dr. Venkata Ramana
DRDO-BU Center for Lifesciences, Bharathiar University Campus,
Coimbatore, Tamil Nadu, India-641046
Email: ramana.micro@gmail.com
9. Fungi in food bioprocessing
Dr. Shalini Singh
IIT Jammu
Email: shalinisingh.iit@gmail.com
10. Fungi in food processing of biobased products
Dr. Ram Naraian
Associate Professor,
Department of Biotechnology,
Mushroom Training and Research Centre,
Faculty of Science,
Veer Bahadur Singh Purvanchal University
Jaunpur-222003 (U.P.)
India.
Phone: +91-9453037072,
+91-8604793064
Email: ramnarain_itrc@rediffmail.com
11. Fungal production of food supplements
Prof. Marcela Claudia Pagano
Department of Plant-Microbial Interaction,
Federal University of Ceará
Brazil
Email: marpagano@gmail.com
Index
